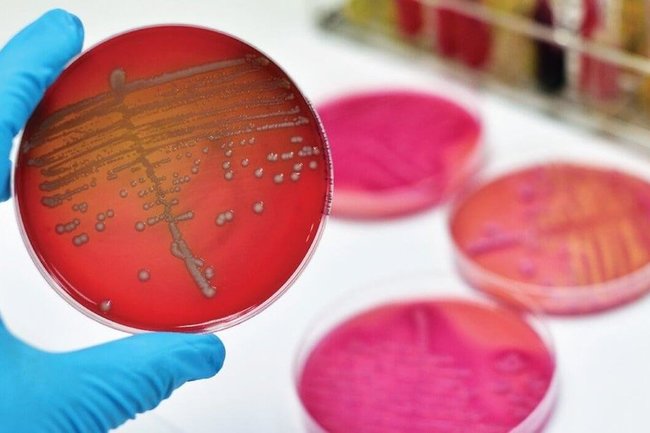

Опасное заболевание: сепсис и инфекционные болезни

Раздел: Экспозиция интеллекта